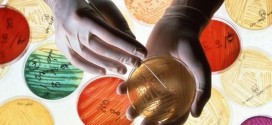
Antibiotics resistance: Drug firms 'to blame', Report

Motley Crue Biopic ‘The Dirt’ Moves Forward With New Production Company, Focus Features executives have acquired the rights to the film, which is based on the band’s bestselling autobiography The Dirt: Confessions of the World’s Most Notorious Rock Band.
Read More »World
Tupac Shakur Exhibit coming to Grammy Museum
Tupac Shakur exhibit to open at Grammy Museum. The changes hitmaker’s belongings, including clothes, cassettes and handwritten notes, will be displayed to the public at the All Eyez on Me: The Writings of Tupac Shakur exhibit.
Read More »Antibiotics resistance: Drug firms ‘to blame’, Report
Drug companies’ poor practices are to blame for the rise of antibiotic resistance which threatens to make even the smallest infections deadly, one industry chief executive has claimed. Doctors have usually been blamed for bacterial resistance because of overprescription, but Karl Rotthier, the chief executive of Dutch-based DSM Sinochem Pharmaceuticals, claims lax procedures at drug firms are the real cause.
Read More »Stress may keep us from empathizing with strangers, New Study
According to a new study published in the journal Current Biology, stress suppresses the ability to empathize with strangers. Empathy is the ability to share and feel another’s emotions. According to researchers, being around strangers generates stress in people, which in turn, diminishes empathy.
Read More »Shooting in Florida mall : Man wounds his wife, kills himself (Video)
A shooting Saturday morning at a mall in central Florida left two people dead and one other injured in what police called a “domestic situation.” Police in Melbourne, Florida, said the gunman — identified as Jose Garcia Rodriguez, 57 — shot his wife, Ida Garcia, 33. Melbourne Police said they believe Rodriguez then turned the gun on himself and died …
Read More »Baker City : 4 injured in massive crash involving 50 vehicles on I-84
Baker City – Police believe weather is to blame for a crash involving dozens of vehicles that forced the closure of a long stretch of Interstate 84 in Eastern Oregon.
Read More »Tiffani Thiessen : ‘White Collar’ Star Expecting Second Baby!
Tiffani Thiessen, 40, and her husband Brady Smith are happy to announce that they are going to become a family of four! “We are excited to announce the news that we are expecting. Harper could not be more thrilled to have a sibling and a playmate,” Tiffani, 40, wrote on her Instagram page today after revealing the exciting news to …
Read More »Miley Cyrus : Singer Full Frontal In V Magazine Disgusts Boyfriend’s Mom
Miley Cyrus nude photos for V magazine might have been approved by her boyfriend Patrick Schwarzenegger but the same couldn’t be said of his mother, Maria Shriver. Reports claim that Shriver finds the photos scandalous.
Read More »Don Harron : Actor, Anne of Green Gables adapter dies at 90
Don Harron, who created the Canadian comedic icon Charlie Farquharson during a decades-long career in show business, has died at his Toronto home. He was 90. He first began his career on CBC radio programs and the American variety show Hee Haw. He also performed during the inaugural season of the Stratford Festival in 1953. In 2007, Harron received a …
Read More »Bruce Jenner Transforms Into a Woman in Magazine Cover (Photo)
Bruce Jenner, 65, should be fuming! The reality star was on the cover of InTouch Weekly, Jan. 14, with bright red lipstick and he almost looked unrecognizable. Kris Jenner was reportedly furious when she saw the cover and we can understand why but now Page Six claims that not only is this photoshopped, but it was actually his face pasted …
Read More »New clinic to bring back abortion services in Fredericton (Video)
Reproductive New Brunswick says a new clinic set to open in Fredericton that will offer abortions is a major step forward for access to reproductive services in the province. Spokeswoman Jessi Taylor says Clinic 554 will open at the site of the former Morgentaler Clinic in the coming weeks after a fundraising campaign raised more than $125,000 to help it …
Read More » Canada Journal – News of the World Articles and videos to bring you the biggest Canadian news stories from across the country every day
Canada Journal – News of the World Articles and videos to bring you the biggest Canadian news stories from across the country every day